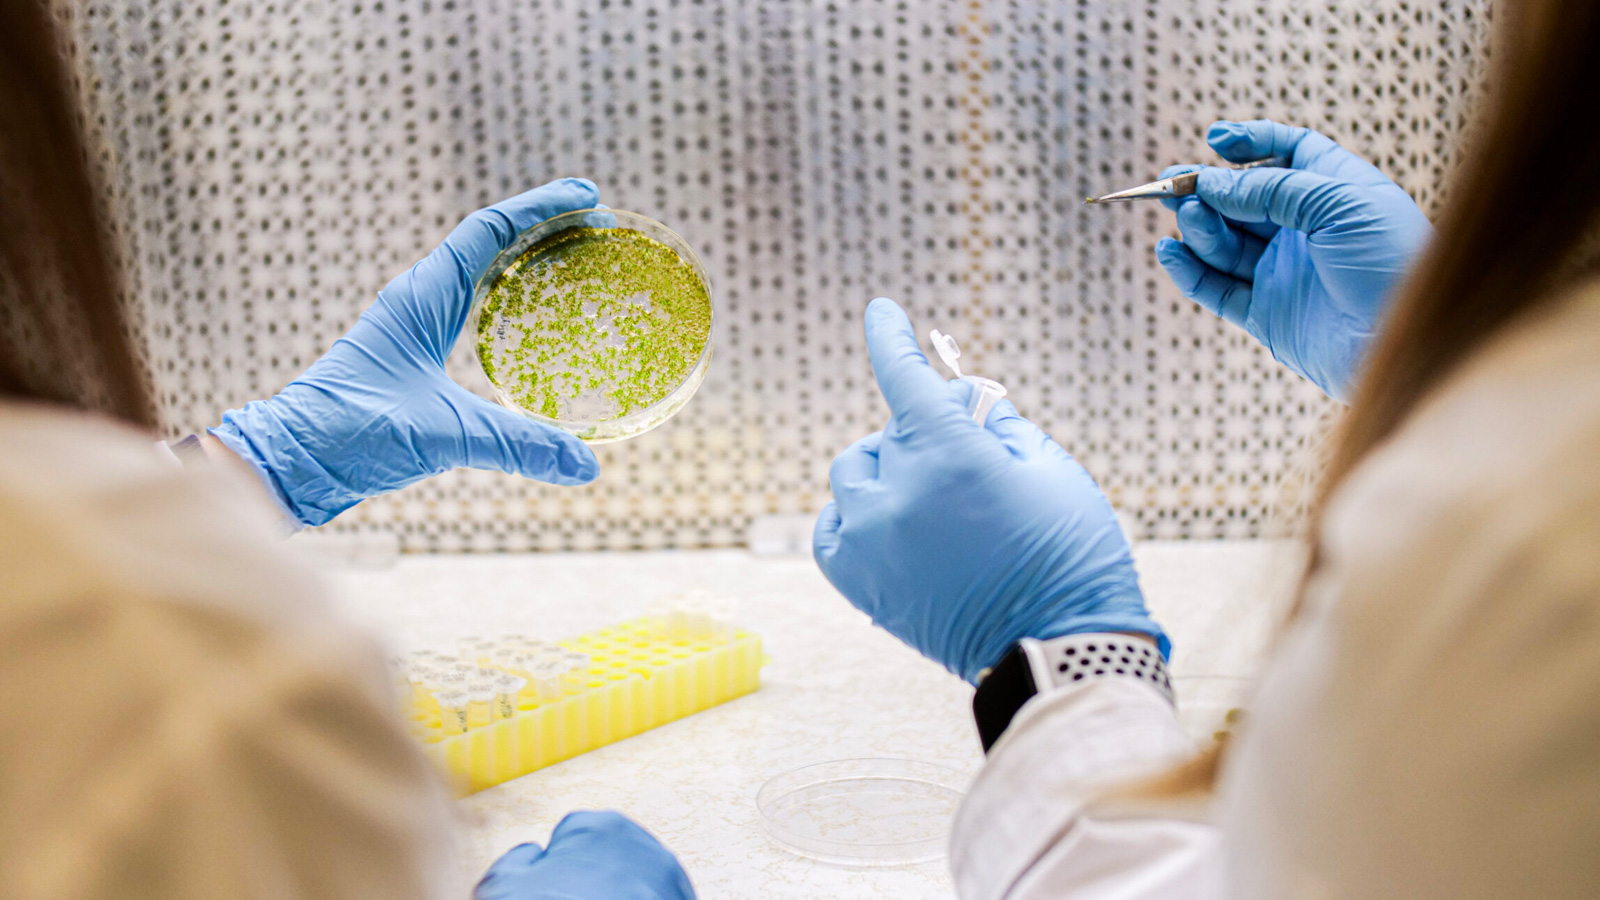

Antarka
Repairing the past, protecting the future of your skin.
* Data source: Crunchbase
- Founded
- 2023
- Employees*
- 4
- Funding to Date*
- $750,000 USD
- Website
- www.antarka.bio
"From Antarctica’s harshest conditions, we bottled nature’s most powerful defenses to transform skin health through DNA repair."
Signed partnerships with 5 key strategics in 4 months within their batch.
Antarka is redefining skincare with next-generation photolyases—specialized enzymes that repair DNA damage caused by UV radiation. Sourced from Antarctic microorganisms, they deliver 100% DNA repair efficacy, offering the best-in-class solution to combat the root cause of skin aging: DNA damage.
More Companies